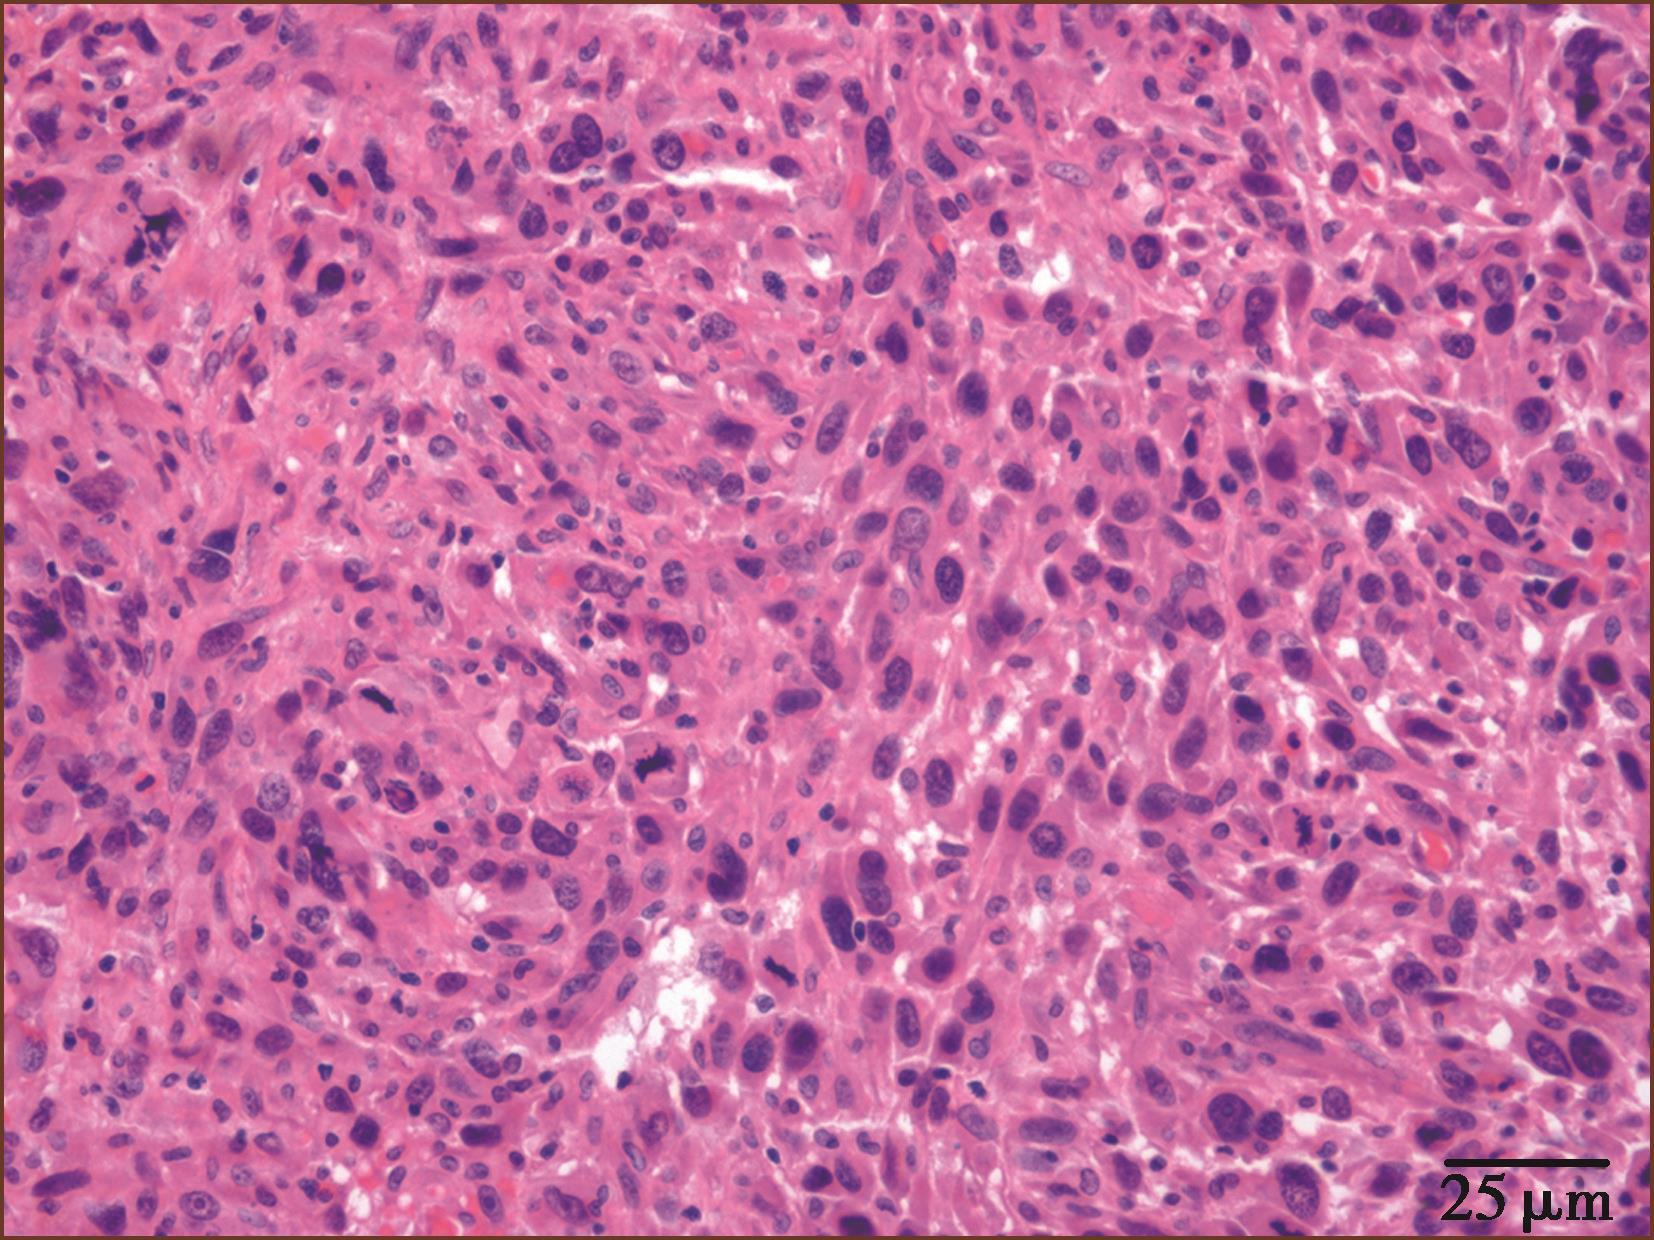

第三章
废血管病病理学

第一节 肺动脉高压病理学
肺动脉高压(pulmonary hypertension,PH)是一大组由不同疾病引起的肺血管压力升高,肺血管阻力增加,肺血管结构改变为特征的临床-病理生理综合征,临床诊断标准为静息状态下右心导管测定肺动脉平均压≥25mmHg。2009年欧洲心脏病协会(ESC)和欧洲呼吸协会(ERS)联合提出肺动脉高压最新分类,将肺动脉高压分为五大类,即第一类动脉性肺动脉高压、第二类左心疾病相关性肺动脉高压、第三类肺疾病及缺氧相关性肺动脉高压、第四类慢性血栓栓塞性肺动脉高压和第五类原因不明和多原因的肺动脉高压。国内外临床现有的任何影像技术、血管内超声(IVUS)及光学相干断层扫描(OCT)、分子实验室等等检查,迄今很难发现微小血管病变,如丛状病变、微血栓等等,这些新技术不能代替病理组织学检查。因此造成诊疗失误时有发生。下面分别叙述几类肺动脉高压的病理学特征性变化及从临床病理资料看临床当前发展中的某些困惑。
一、动脉性肺动脉高压
动脉性肺动脉高压(pulmonary arterial hypertension,PAH)包括特发性肺动脉高压(idiopathic PAH,IPAH)、遗传性肺动脉高压(heritable PAH,HPAH)、药物及毒物引起的肺动脉高压、相关疾病继发性肺动脉高压(associated with PAH,APAH),APAH包括先天性体-肺循环分流畸形(先天性心脏病)、结缔组织病、门静脉高压、人体免疫缺陷病毒(HIV)感染相关的PAH等等。此类中还包括新生儿持续(胚胎)性PAH(persistent pulmonary hypertension of the newborn,PPHN)、肺静脉阻塞病(pulmonary veno-occlusive disease,PVOD)、肺毛细血管瘤样增生(pulmonary capillary haemangiomatosis,PCH)、肺小动脉纤维肌性结构不良(pulmonary fibromuscular dysplasia,FMD)也属于PAH。
(一)动脉性肺动脉高压(PAH)的特征性病理改变
直径大约<500μm的远端肺动脉(small pulmonary artery,sPA)中层肌性肥厚,微细动脉肌型化,内膜纤维性增生增厚可分为向心性、偏心性、非板层状及/或板层状纤维性增厚使管狭窄、闭塞,可并发血栓形成。在重症PAH可出现肺细小动脉丛状病变及扩张性改变,坏死性动脉炎,并可见微血管瘤样增生等。肺小动脉外膜亦可见纤维性增厚。弹力型肺动脉内膜可见内膜粥样硬化;晚期形成右心室肥厚扩张,肺源性心脏病,心力衰竭。
1.肺小动脉中膜肥厚
肺内肌型小动脉的外径通常为0.1~1mm,中膜肥厚即内外弹力板之间的动脉中层平滑肌细胞数量及大小的增加导致中膜厚度增加(图3-1-1)。肺小动脉平均中膜厚度大于外径的10%以上即可定为PH中膜肥厚,在成人肺动脉高压中膜厚度通常会达到15%,儿童则为25%,而肺微细动脉则可达到35%。
肺动脉高压肺小动脉中膜肥厚的另一个表现为肺微细动脉肌型化(图3-1-2)。在正常成人肺组织中,外径100μm以下的微细动脉中膜没有连续的平滑肌层。在肺动脉高压时微细动脉中膜可见连续的平滑肌层(图3-1-2)。
2.肺小动脉内膜增生
肺动脉高压继续发展,伴随着中膜肥厚将会发生内膜细胞增生及纤维性增厚(图3-1-3);但在儿童某些类型先天心脏病(先天性心脏病)伴发的PAH和成人弥漫性肺泡损伤伴发PH时,肺小动脉可以仅仅表现为内膜增生而没有中膜肥厚。内膜的细胞数量和大小都可增加,向管腔生长时往往呈放射状而非同心圆性。内膜增生纤维化也可发生在其他肺血管病中,如先天性心脏病法洛四联症型肺血管病变及慢性肺疾病中。

图3-1-1 肺小动脉中膜肥厚(ET+VG染色,中倍放大)

图3-1-2 微细动脉肌型化(ET+VG染色,中倍放大)

图3-1-3 肺小动脉内膜细胞性增生(Masson染色,中倍放大)
肺小动脉内膜胶原和弹力纤维组织增生,内膜纤维组织可呈偏心性或向心性板层体样或非板层体样增生。因为胶原纤维增多,内膜呈嗜伊红性,最终玻璃样变性,纤维细胞消失(图3-1-4)。在严重的PH病例,内膜纤维性增生可以阻塞动脉管腔。内膜广泛纤维化性狭窄是永久性的血管损伤,往往提示患者预后不良(图3-1-5~图3-1-7)。内膜纤维化在大多数的肺纤维化中为局部病变,而在硬皮病、系统性红斑狼疮和类风湿疾病相关的肺动脉高压中呈弥漫性病变。

图3-1-4 肺小动脉内膜细胞性增生(HE染色,中倍放大)

图3-1-5 肺小动脉内膜分层状纤维性增厚(似洋葱断面),管腔重度狭窄(HE×400)
阻塞性内膜纤维化应该与肺动脉机化血栓鉴别,后者可产生继发性肺动脉高压,且有着不同的组织发生。在机化血栓,可以见到残余的纤维素、多个迂曲的毛细血管、广泛的弹性组织变性和内中膜交界消失(图3-1-8)。在机化血栓基础上的肺动脉高压有偏心性内膜纤维化,在纤维化的内膜中会一个大的、残余的半月形的腔或多个小的腔隙(图3-1-9)。而肺动脉高压中肺小动脉同心性内膜纤维化则只有一个管腔。

图3-1-6 先天性心脏病肺小动脉内膜纤维性增生增厚,管腔重度狭窄,远端有丛状病变。患者术中死亡(Masson染色,中倍放大)

图3-1-7 肺小动脉内膜纤维性增生增厚,管腔狭窄(ET+VG染色,中倍放大)

图3-1-8 肺小动脉机化血栓再通,可见多个大小不等的腔隙(ET+VG染色,中倍放大)
3.丛源性肺动脉病
在大多数严重的PAH,肌型肺动脉和肺微细动脉可发生纤维素样坏死(图3-1-10,图3-1-11)。坏死通常是节段性的,可发展成为动脉瘤样破裂,伴发间质或肺泡腔内出血,最终含铁血黄素沉积。局部修复性的重建血管瘤样的结构就是丛状病变(plexiform)。丛状病变是Ⅳ级肺动脉高压的标志。

图3-1-9 肺小动脉内膜纤维化合并血栓形成,阻塞管腔(HE×400)

图3-1-10 PAH患者肺动脉壁纤维素样坏死伴动脉炎(HE染色,高倍放大)

图3-1-11 PAH患者肺动脉壁纤维素样坏死伴动脉炎(Masson染色,高倍放大)
丛状病变组织学显示由无规律生长的内皮细胞团(丛)状增生(有作者认为是肿瘤性内皮细胞增生)(图3-1-12,图3-1-13)。丛状病变组成成分有新生内皮细胞团(丛),混杂有肌纤维母细胞、平滑肌细胞和结缔组织基质,形成灶性薄壁的多个毛细血管裂隙。丛状病变的内皮细胞可被血管内皮生长因子(VEGF)和它的受体标记;用α-SM-Actin可以标记丛状病变内的肌纤维母细胞。有的作者形容丛状病变为血管球样生长。有时,丛状病变的管腔宽大,病变类似动静脉畸形。如果管腔内含有纤维素,要与机化血栓进行鉴别。在临床PAH中,丛状病变在肺活检组织中不易见到。在重症PAH一张组织切片上能见到一两处丛状病变,因此至少应该检查10个肺组织块,才能够除外丛状病变。有研究报道,特发性肺动脉高压的丛状病变为单克隆来源;反之在继发性肺动脉高压的丛状病变是多克隆来源。

图3-1-12 IPAH患者的肺小动脉的丛状病变(HE,中倍放大)

图3-1-13 先天性心脏病患者的肺小动脉的丛状病变(HE,中倍放大)
丛状病变可见在肺小动脉腔内(见图3-1-5)、好发于血管分叉处;也可侵入血管向肺小动脉外形成管壁外丛状病变(见图3-1-13);在丛状病变内还可见纤维素新血栓和血小板积累(图3-1-14)。丛状病变在PAH的发生率变异很大,有报告累及肺动脉分支的20%~60%。
与丛状病变相关的后续病变是丛状病变后端的动脉扩张性病变(图3-1-15,图3-1-16),即血管扩张,中膜几乎消失,有时似肺小静脉。扩张性病变的血管可以是直的、纺锤形的或者团状类似海绵状血管瘤。或者表现为局部、薄壁的球样膨出类似动脉瘤。血管扩张性病变一般认为是近端血管狭窄后的继发性扩张,是坏死性动脉炎的直接结果。偶尔,在程度较轻的PAH中缺乏丛状病变,而仅见血管扩张性病变单独存在。

图3-1-14 来自IPAH患者的肺小动脉丛状病变,多个厚薄不一、形状多样的小血管球状及丛状增生,即丛状病变,周围有组织坏死及大量淋巴细胞浸润,为坏死性动脉炎(HE,中倍放大),F:丛状病变
我们在IPAH的尸检肺新鲜标本,从肺门肺动脉注入微粒钡剂,然后取材石蜡制片,显微镜检查,见丛状病变内及其后端血管腔内无钡剂,而其他开放的肺小动脉腔内含有钡剂,说明丛状病变引起了肺小动脉明显阻塞,使钡剂不能通过。

图3-1-15 晚期丛状病变,图下端是小血管球状增生,图上端血管腔扩大似静脉壁,为肺小动脉丛状病变后的血管扩张性病变(Masson染色,高倍放大)

图3-1-16 来自IPAH,图右上方肺小动脉腔呈筛孔状,腔内可见注射的深色钡剂(∗),图中下部的丛状病变裂隙内血管无钡剂,其他薄壁血管为扩张的肺小动脉(HE,高倍放大)
有报道指出,丛状病变在特发性IPAH多累及较小(小于外径100μm)的肺动脉,最小至直径小于79μm的动脉;而在继发性PAH的丛状病变趋向于在较大的肺动脉,如在先天性心脏病艾森门格综合征,丛状病变可见于210μm以上的肺小动脉。因此现在临床除用病理技术以外的任何检查不能发现丛状病变和坏死性动脉炎。
丛状病变多发生在儿童或成人严重的未经矫治的先天性左向右分流性心脏病中,也常见于年轻人快速进展的IPAH中,可见于服用抑制食欲的药物如阿米雷司的患者、重症肺胶原病、HIV或丙型肝炎病毒感染相关的APAH中。血管纤维素样坏死和丛状病变很少见于2岁以下的患者,即使患儿的肺动脉压力很高。在2岁以下的肺动脉高压患者,肺小动脉闭塞性改变比血管纤维素样坏死和丛状病变更为重要,同时肺内小动脉和微细动脉数量会减少。
丛状病变、血管扩张性病变和坏死性动脉炎,统被国际病理界称为不可逆性 “重度肺动脉高压的复合性病变”。
(二)特发性肺动脉高压(IPAH)
IPAH,即原因不明的PAH,过去称为原发性肺动脉高压(primary pulmonary hypertension,PPH),现被称为特发性肺动脉高压。IPAH病理改变见图3-1-12,统归为动脉性肺动脉高压。尽管Heath和Edwards的肺动脉高压病理分级法是在观察先天性心脏病肺血管改变的基础上提出的,其中丛状病变是这一分级系统中PAH不可逆的标记,也有研究表明85%的IPAH中存在丛状病变。因此有作者建议将IPAH合并血栓形成和/或丛状病变单独列为特发性肺动脉高压的特殊类型。经过改良,现在判断肺动脉高压的分级标准为四级分法(表3-1-1)。
表3-1-1 肺动脉高压中肺动脉病变改良Heath-Edwards分级法

(三)有血液分流的心血管畸形所致肺动脉高压及病变可逆性的判断
此类又称为高动力性(肺血流增加性)肺动脉高压,此种心血管畸形所发生的肺动脉高压,进一步分为单纯三尖瓣前型(如房间隔缺损、肺静脉畸形引流);单纯三尖瓣后型(室间隔缺损、动脉导管未闭);组合分流(以上两种分流组合);复杂畸形(完全性心内膜垫缺损、单心室、大动脉转位伴室间隔缺损和/或动脉导管未闭、共同动脉干、三腔心等)。几乎所有的动脉共干、约50%的室间隔缺损、10%的房间隔缺损发生肺动脉高压性肺血管病,PAH肺血管病与间隔缺损大小有关。先天性心脏病并发严重PAH病变影响心脏畸形矫正手术的效果。此种肺血管高压性病理改变与前述,其肺血管改变主要累及肺小动脉及微细动脉,晚期才继发肺小静脉、细静脉内膜纤维化。多数患者肺组织无明显病变。当合并肺炎或肺间质炎时可伴有肺实质或间质性病理改变。有的先天性心脏病伴发肺细小血管、肺泡或细淋巴管发育畸形,造成矫正手术后死亡。
如何评估PAH病变为可逆或不可逆性病变,是迄今尚未明确而又重要的问题。Heath和Edwards首先提出先天性心脏病PAH病变分6级方法:Ⅰ级:肺小动脉中层肥厚;Ⅱ级:肺动脉中层肥厚及内膜有细胞性增生;Ⅲ级:出现肺动脉阻塞性内膜纤维化;Ⅳ级:出现丛状病变;Ⅴ级:在前Ⅳ级改变基础上出现肺动脉扩张性病变等;Ⅵ级:出现坏死性肺动脉炎。Wagenvoort等在此基础提出4级分法,他们同意前述Ⅰ、Ⅱ、Ⅲ级的分级条件,但认为前述Ⅳ、Ⅴ和Ⅵ级均属重度病变可归纳为一级(Ⅳ级)。
在实际工作中我们体会Ⅰ级、Ⅱ级与Ⅲ级病变可存在于同一病例,由于缺乏适用的形态定量标准,对于血管狭窄或闭塞病变的密度、发生比例难以估计,故不易准确分级。结合我院先天性心脏病尸检40例及100余例先天性心脏病PAH肺活检组织病理检查与心导管资料及心脏畸形矫正手术效果的对照分析,我们将PAH性病变分为四级:Ⅰ级(轻度):指有较多(1/3以上)支肺肌型动脉中层肥厚及微细动脉肌型化(图3-1-1,图3-1-2);Ⅱ级:为肺肌型动脉中层肥厚+1/3以上肺动脉分支的内膜细胞性增厚(图3-1-3,图3-1-4)或少于1/3支的内膜轻度纤维化;Ⅲ级:为肺肌型动脉中层肥厚及1/3以上分支的肺动脉管腔被内膜纤维化阻塞或狭窄,或伴有广泛的肺泡间质纤维化;Ⅳ级:为肺肌型动脉中层肥厚、内膜纤维化,并出现肺动脉丛状病变(图3-1-5,图3-1-12~图3-1-16),有或无肺动脉壁局限性纤维性素样坏死、水肿、及/或炎细胞浸润(图3-1-10,图3-1-11,图3-1-14)。
如肺小动脉出现丛状病变、较广泛的肺小动脉板层状纤维性闭塞(图3-1-7)、动脉壁灶性坏死、动脉炎或广泛肺间质炎等,则应视为先天性心脏病矫正手术或介入治疗的禁忌证。丛状病变多见于肺下叶。严重肺动脉高压可发生肺动脉干瘤样扩张。组织学显示此种肺动脉干中层广泛黏液样变性、小囊性坏死。在先天性心脏病丛状肺动脉病时各种体-肺循环侧支吻合也可增加。
文献及阜外医院患者的临床病理资料表明,Ⅰ、Ⅱ级病变属可逆性,心血管畸形矫正手术后肺动脉高压下降,可恢复到正常水平;Ⅳ级(近似六级分类法的Ⅳ、Ⅴ、Ⅵ级病变)为不可逆性病变。阜外医院病理分级中的Ⅲ级属临界性病变,此级患者术后有的遗留持久性肺动脉高压,有的肺动脉高压可几乎恢复正常。我院的资料说明,肺动脉收缩压与体动脉收缩压的比值≥0.92及肺动脉平均压≥8.66kPa(65mmHg)、肺血管阻力≥1200dyn·s/cm 5 者,矫正手术远期效果不好,即使矫正手术成功,多数患者肺动脉高压持续不降,甚至发生右心衰竭死亡。Wilson等报道,体循环与肺血管阻力比率>0.45,肺血管阻力>7U/m 2 ,可预测肺动脉高压为不可逆性。但术后致死性肺动脉高压危象也可发生在sPA可逆性(PAH 1级)病变或肺活检肺动脉正常者。冷冻切片不足以估计肺血管病变(错误率9%),需连续切片(有人认为切片30张/例),显微镜观察。
如将肺血管病理改变与患者的血流动力学及临床资料综合分析,判断预后较为准确。在先天性心脏病PAH与丛源性肺动脉病可用此分级法判断PAH可逆与不可逆,而在其他类型的PAH不宜应用此分级法来判断病情。Yamaki等报道91例Ⅱ孔型房间隔缺损致重度PAH(肺动脉收缩压>70mmHg)及/或肺血管阻力>8U/m 2 ),取右中叶肺活检,切片30张/例,将肺血管病变分4型:①肺小动脉肌肉弹力纤维增生(musculoelastosis),内膜含纵行肌束及弹力纤维增生。此种病变均可行矫正手术。②丛源性肺动脉病32例中25例做了矫正手术,余7例在随访中。③肺小动脉血栓阻塞5例,全部适应了矫正手术。④丛源性肺动脉病及肺小动脉肌肉弹力纤维增生混合型:如未发现体-肺侧支循环则适宜矫正手术。作者认为肺活检的病理判断对选择矫正手术是很有意义的。有报道2岁以下先天性心脏病PAH不适用上述病理分级法判断手术指征。
我们将肺小动脉高压性病变分级与血流动力学资料、肺气血屏障及微循环系的超微结构、手术效果等互相对比分析,说明肺小动脉的PAH病理改变程度是判断预后的主要依据;而肺气-血屏障、静脉和毛细血管的显微及超微结构改变的程度与预后对比分析,发现无规律性关系。
我们通过免疫组织化学研究PAH的肺小动脉发现,Ⅰ、Ⅲ型胶原见于肺动脉外膜、中膜及内膜纤维化区。Ⅳ型胶原见于肺动脉中膜层平滑肌细胞、内皮细胞的基底膜及内膜早期纤维化区、肺泡壁毛细血管基底膜及支气管壁。Ⅰ型胶原增多趋向于为不可逆性PAH,而Ⅳ型胶原增多属于可逆性PAH病变。
(四)与肝硬化门静脉高压相关的肺动脉高压
在下述两种肝脏疾病中,少数人可并发肺动脉高压:一是肝硬化,二是门静脉血栓形成。约<1%~2%的肝硬化患者伴发PAH,可以在没有动脉低血氧者也发生PAH。并发此种PAH原因及发病机制不清楚,其肺小动脉可产生中层肥厚,内膜纤维化及丛状病变,肺毛细血管充血扩张。如出现此类肺动脉高压性血管病变,要注意与先天心血管分流畸形和原因不明的肺动脉高压区别。我们见1例女性,15岁,心慌、气短、下肢水肿1年,因咳嗽、咳痰、发绀,从湖北血吸虫疫区来我院。查心尖部有Ⅲ级收缩期杂音,心电图示右心室肥厚,心音P2>A2,因室颤死亡。临床诊断为先天性心脏病,室间隔缺损。尸检见:右心室右心房显著增大,心脏血管无先天畸形。两肺内散在多个陈旧血吸虫卵结节及灶性纤维化,肺细小动脉中层肥厚,内膜细胞增生使管腔狭窄,肺细小动脉有多个丛状病变形成;肝脏结节性硬化,有血吸虫卵结节。结肠黏膜有溃疡及血吸虫卵结节。尸检病理诊断:血吸虫病性肝硬化致丛状肺动脉高压,慢性肺源性心脏病。此例临床未想到肺动脉高压,忽视了患者来自血吸虫病疫区、有慢性血吸虫病肝硬化史及并发丛状肺动脉病、肺动脉高压的征象,因而误诊。
(五)人类免疫缺陷病毒感染(HIV)相关的肺动脉高压(HIV-PAH)
一项2008年的调查资料表明PAH在HIV感染者中的发生率为0.5%,是普通人群肺动脉高压发生率的25倍,其病理学特征主要是肺小动脉中膜肥厚,内膜增生、纤维化,丛状病变多见(78%的病例可见),肺血管炎细胞浸润明显。
HIV感染引起肺动脉高压的机制有几个方面,机制一,HIV感染引起内皮功能失调。HIV病毒抗原在肺动脉内皮细胞表达直接导致内皮细胞凋亡、生长和增殖失调。HIV与巨噬细胞结合的必需蛋白-糖蛋白120-以内皮细胞为靶向,增加凋亡标记物的表达,刺激内皮细胞分泌内皮素1(ET-1)引起肺动脉高压的发生。机制二,HIV感染引起肺动脉炎症。炎症在肺动脉高压十分普遍,在HIV-PAH尤为突出。HIV感染引起慢性炎症和持续性免疫反应激活和下调,间接引起前炎因子和生长因子的释放,是肺动脉高压发生的机制之一。其中血小板源性生长因子(PDGF)的表达增加可以刺激平滑肌细胞和纤维母细胞的生长和迁移,在肺动脉高压中可以见到。另外,HIV感染引起的T淋巴细胞产生的血管内皮生长因子A亦可引起血管通透性的改变和内皮细胞的增殖,在肺动脉高压发生中发挥作用。机制三,HIV病毒的负性因子(nef)的作用。Nef是HIV病毒在宿主寄居并与宿主信号相互作用的重要抗原,在HIV感染的患者肺内和血管细胞均可检测到。在体外,暴露于nef的内皮细胞增殖增加,而后凋亡增加。在比较嵌合型SHIV(猿猴-人免疫缺陷病毒)nef病毒(将人类HIV nef基因构建到SIV的嵌合型病毒)感染的灵长类和感染野生型SIV(猿猴免疫缺陷病毒)nef的灵长类动物肺组织时发现,SHIV nef感染的动物肺内丛状病变十分常见,nef抗原位于肺血管内皮细胞。Voelkel等认为nef被内皮细胞摄取可以引起细胞凋亡,这些凋亡体被邻近的细胞胞吞后产生凋亡抵抗细胞,因此内皮细胞增殖失去控制而过度增殖,形成丛状病变。
(六)肺小动脉发育异常引起的肺动脉高压
1.肺小动脉纤维肌性结构不良(pulmonary fibromuscular dysplasia,FMD)
肺小动脉纤维肌性结构不良患者临床及影像学检查表现为不明原因的肺动脉高压。光镜组织学检查,发现肺肌型动脉中层肥厚,中膜肌纤维、胶原纤维及弹力纤维异常不均匀增厚,连同内膜层呈乳头状(图3-1-17)或锯齿状突向动脉腔,或在动脉腔内迂曲,使动脉腔被填塞呈裂隙状。但未见丛状病变、血管炎。邻近肺组织、气道无明显病变。此种异常肌肉、弹力纤维、胶原纤维束发生在肺小动脉的中膜层,称为肺动脉纤维结构不良的中膜型,如发生在内膜层则为内膜型,发生在动脉外膜层则为外膜型,但以中膜型多见。肺小动脉纤维肌性结构不良在临床上引起不明原因的肺动脉高压,主要靠病理组织学检查确诊。我们报道了2例属中膜型FMD。如临床想到此病,开展肺活检,加上病理医师掌握本病的病理变化特征,确诊不难。

图3-1-17 肺小动脉肌层显著增厚,由自肌层向动脉腔内异常生长的肌纤维、胶原及弹力纤维呈乳头状突向管腔,造成管腔阻塞(ET+VG,×200)。FMD:纤维肌性结构不良
2.肺动脉-静脉瘘
肺动脉-静脉瘘(pulmonary arteriovenous fistulae)为肺动脉、静脉之间先天性连接异常。患者开始无症状,以后出现呼吸困难、发绀、咯血。血管分流一般是右到左,但如支气管动脉也参与了此种畸形,可见双向分流。肺内可见扩大的但大、小不一的囊腔或血管腔,由薄壁类似静脉的宽大、但大小不一、形状不规则的血管形成。在组织切片上可见宽大肥厚的肺肌型动脉,纵切呈多枝状。肺肌型动脉与支气管、细支气管无关系。也可见到大小不一的静脉与动脉直接互相沟通,在弹力染色的切片上显示一侧为肥厚的动脉、有双层弹力板,另一侧为静脉样结构(图3-1-18)有的病例可见内含许多扩大、薄壁的丛状血管(telangiectases)。肺动脉-静脉瘘多在外科标本(一肺段或肺叶内)被发现,很少见于肺活检标本。肺动-静脉瘘继发慢性肺动脉高压后可见肺小动脉中层肥厚、内膜纤维化,新旧血栓形成,管腔狭窄。也可产生肺小静脉内膜纤维化,新旧血栓形成;但未见丛状病变。在临床上肺动脉-静脉瘘有的被误为先天性心脏病,有的被误为慢性肺结核。

图3-1-18 肺小动脉一侧明显不均匀性增厚(∗),另一侧壁薄似静脉(箭头所示),内膜轻度纤维化(ET+VG, ×200)
(七)肺静脉阻塞病
肺静脉阻塞病(pulmonary veno-occlusive disease,PVOD),以前称肺阻塞性静脉病(pulmonary occlusive venopathy)。此种肺动脉高压很少见。临床表现类似IPAH,主要靠病理组织学确诊。病理组织学表现为广泛的大小不一的肺细小静脉纤维化阻塞,阻塞的纤维组织可以是松散的水肿样,含有不同种细胞;或为静脉内致密的无细胞性纤维化。病变很少累及大的肺静脉。静脉病变或为少数偏心性,或为多发偏心性纤维化-来自血栓的机化。PVOD累及的细小静脉中层可见弹力纤维和平滑肌细胞增多而增厚、出现双层弹力板-被称为静脉动脉化(arterialization)。以上病变有助于与被动性肺静脉高压区别。在慢性被动性肺静脉高压,其静脉、毛细血管充血,原发于心脏瓣膜病或大肺静脉疾病。另外,PVOD的肺小静脉壁和附近肺泡壁存在钙化物质包绕的弹力纤维和由此引起的异物巨细胞反应,也是除外被动性肺静脉高压的组织形态之一,但这是非特异性的。当遇到间质性肺病或肺气肿的静脉病变时,这种钙化反应病变也可作为识别肺静脉阻塞病的辅助条件。肺细小动脉结构改建约见于50%的PVOD患者。
(八)肺毛细血管瘤样增生症
肺毛细血管瘤样增生(pulmonary capillary haemangiomatosis,PCH)是另一罕见的肺动脉高压,特征是在肺组织内有局限性毛细血管、小静脉增生,增生的微血管侵入肺间质、血管或气道周围成团块状,低倍镜下类似肺充血,仔细观察为弥漫性微血管增生,内含大量红血细胞。此增生的微血管可形成球状或结节状,增生的内皮细胞中少见核分裂象。异常增生的微血管可侵至肺细小动脉、细小静脉壁并阻塞管腔,也可侵入附近的神经、胸膜和淋巴结。
在肺微血管病,可见肺小动脉明显的肌性肥厚及内膜纤维化增厚。但不像PVOD,血栓形成不是其特征。静脉闭塞在PVOD是由于内膜纤维化;而在肺微血管病则是由于微血管增生。在肺微血管病未见丛状病变。
关于本病的发生学说,争论不一。肺微血管病在临床表现类似IPAH,主要靠组织病理学来鉴别和确诊。我们遇到的肺微血管(细小静脉和/或毛细血管)瘤样增生是在丛源性肺动脉病、COPD-PH和风湿性二尖瓣病的尸检肺组织内。
我们未见单独的肺阻塞性静脉病或肺微血管病或肺毛血管瘤样增生的肺动脉高压病例。
二、与左心疾病相关的肺动脉高圧
国际肺动脉高圧分类中称为与左心疾病相关的肺动脉高压(pulmonary hypertension associated with left heart diseases),亦有称静脉型或称慢性被动性(毛细血管阻力性)肺动脉高压,凡累及左心房、左心室、二尖瓣、主动脉瓣的各种疾病,各种原因引起的慢性左心衰竭、左心疾病,如二尖瓣、主动脉瓣狭窄、肺静脉病、左心房黏液瘤、三房心、晚期高血压病、冠心病、心肌病、二尖瓣替换术后的机械瓣失灵、左心房血栓或左心房肿瘤阻塞等,均可引起静脉型肺动脉高压。其病理特征是病变累及肺静脉,也累及肺动脉(图3-1-19)。其中静脉改变比动脉性肺动脉高压的肺静脉病变的发生早而重。肺小静脉、小动脉、毛细血管高度充血。静脉型肺动脉高压可产生肺细、小静脉中层肥厚、静脉 “动脉化”和内膜纤维化,常伴发肺泡间质充血、纤维化及含铁血黄素沉着。肺泡腔有多量含铁血黄素吞噬细胞(图3-1-20)即心力衰竭细胞,肺细小动脉也可产生中层肥厚(提示有PH),内膜纤维化;但未见有丛状病变的报道,也很少见肺动脉坏死或动脉炎症反应。此型与动脉性肺动脉高压不同处,还有肺动脉、静脉病变具有区域性差别:如风湿性心脏病二尖瓣病变患者,其肺动脉、静脉改变在肺底部比肺尖部明显,这种差异与肺下部流体静水压高有关。静脉型肺动脉高压的病变分级标准近似动脉型的Ⅰ、Ⅱ、Ⅲ级改变,既累及静脉,也累及动脉。而动脉性肺动脉高压以sPH动脉病变先发生并更明显,静脉病变少而轻。我们在1例风湿性二尖瓣病的尸检肺组织,发现在高度充血的肺间质内有多灶性肺微血管(细小静脉和毛细血管)瘤样增生。但其内皮细胞未见核分裂象。此种微血管增生可能为慢性严重肺血管淤血的反应性增生。

图3-1-19 肺小静脉充血,内膜明显纤维化增厚致管腔狭窄(ET+VG, ×200)

图3-1-20 风湿性心脏病致肺动脉PH,肺泡腔内充满心衰细胞(ET+VG, ×200)
三、血栓阻塞性肺动脉高压
为肺血流机械阻塞性PH,是慢性肺动脉血栓形成及/或栓塞病所致的肺动脉高压(chronic thromboembolic pulmonary hypertension,CTEPH),详见第二节肺动脉栓塞病理学。
四、缺氧性肺动脉高压
缺氧性肺动脉高压(pulmonary hypertension due to lung respiratory diseases and/or hypoxia)包括慢性阻塞性肺疾病、高原(山)病、间质性肺疾病、睡眠呼吸障碍、肺泡低通气综合征、新生儿肺病、肺泡-毛细血管发育不良、脊柱及胸廓畸形、高度肥胖、特发性含铁血素沉着症等引起的肺动脉高压。缺氧性肺动脉高压对大的肺动脉受影响很少,主要发生肺小动脉中层肥厚,微细动脉肌型化,也可出现肺小动脉内膜纤维化。肺细、小动脉内膜下纵行肌束出现是特征性改变。未见有丛状病变的报道。我们在慢性阻塞性肺疾病导致肺源性心脏病死亡的尸检中查见肺动脉干(占20%)、叶支(90%)的病例有粥样硬化斑块(与慢性肺动脉高压有关),53%有肺细小动脉新旧血栓形成,其中10%的病例出现小灶性急性肺梗死,未发现这些肺梗死患者有体静脉血栓性炎。多数肺小动脉有中层肥厚、内膜纤维化。有的患者既有肺气肿,又合并肺结核或支气管扩张,其肺动脉高压性病变复杂。
五、混合型肺动脉高压
混合型肺动脉高压可见在肺结节病、朗格汉斯(组织)细胞增生症、淋巴管瘤病、肺血管受压(淋巴结肿大、肿瘤、纤维性纵隔炎)等。此类肺动脉主要病变为肺小动脉中层肥厚,微细动脉肌型化,可出现肺小动脉内膜纤维化。
(李莉 阮英茆)
参考文献
1.Galie N,Torbicki A,Barst R,et al.Guidelines on diagnosis and treatment of pulmonary arterial hypertension.European Heart Journal,2004,25(24): 2243-2278.
2.Wagenvoot CA,Mooi WJ.Biopsy pathology of the pulmonaryvasculature.London:Chapman and HallMedical,1989:56-108,114-125,128-147,149-166,170-322.
3.Houser S,Balls UJ,Mark EJ.Current Clinical Pathology: Lung pathology.Totowa: Humana Press Inc,2005:299-344.
4.Pietra GG,Capron F,Stewart S,et al.Pathologic assessment of vasculapathies in pulmonary hypertension.J Am Coll Cardiol,2004,43(12s1): 25s-32s.
5.Peacock AJ,Rubin LJ.Pulmonary circulation:disease and their treatment.2nd ed.London:Hodder Arnold Publication,2004:25-31,45-47.
6.Rubin LJ.Pathology and Pathophysiology of primary pulmonary hypertension.Am J Cardiol,1995,75(3): 51a-54a.
7.Harris p,Heath D.The Human Pulmonary Circulation.2nd ed.London: Churchill Livingstone,1977: 243-550,244-552.
8.Heath D,Edwards JE.The pathology of hypertensive pulmonary vascular disease:a description of six grades of structular changes in the pulmonary with special reference to congenital cardiac septal defects.Circulation,1958,18(4): 533-547.
9.阮英茆,胡旭东,薛淦兴,等.先天性心脏病肺动脉高压性病变与血流动力学资料对照分析。中华心血管病杂志,1983,11(3):165-168.
10.Groverm,Hutchins,Peter J,et al.The pathogenesis of the two forms of hypertensive pulmonary vascular disease.Am Heart J,1976,92(6): 797-803.
11.阮英茆。肺血管病:肺血管病病理学。北京:北京医科大学、协和医科大学联合出版社,1993:49-53.
12.阮英茆,朱晓东,程显声等。先心病肺动脉高压肺活检100例病理分级的临床应用探讨。中国循环杂志,1992,7(1): 54-57.
13.阮英茆,程显声,司文学,等.临床诊断与尸检不符的肺心病11例报告。中国循环杂志,1993,8(6):370-372.
14.阮英茆,司文学,张连庄等。肺动脉高压尸检病例的肺动脉形态计量及胶原变化的观察。中华病理学杂志,1996,25(2): 89-92.
15.阮英茆,朱晓东,程显声,等.先心病肺动脉高压肺部显微及超微病变与临床资料对比分析。中国循环杂志,1993,8(7): 409-411.
16.Wilson NJ,Seer MD,Taylor GP,et al.The Clinical value and risks of lung biopsy in children with congenital heart disease.J Thorac Cardiovasc Surg,1990,99(3): 460-468.
17.Giampietri ZEA,Thelmo WL,Anderson VM.Coarctation of the Left pulmonary artery:effects on the pulmonary vasculature of infants.Pediatr Cardiol,1997,18(5):376-380.
18.Yaginuma G,Mohri H,Takahashi T.Distribution of arterial lesions and collateral pathways in the pulmonary hypertension of congenital heart disease:a computer aided reconstruction study.Thorax,1990,45(8): 586-590.
19.Yamaki S,Kumate M,Yonesaka S,et al.Lung biopsy diagnosis of operative indication in Secundum atrial septal defect with severe pulmonary vascular disease.Chest,2004,126(4): 1042-1047.
20.Maeda K,Yamaki S,Kado H,et al.Reevaluation of histomorphometric analysis of lung tissue in decision marking for better patient selection for Fontan-tyre operation.Ann Thorac Surg,2004,78(4): 1371-1381.
21.Schraufinagel DE,Kay JM.Structural and pathologic changes in the lung vasculature in chronic liver disease.Clin Chest Med,1996,17(1): 1-15.
22.Dominguez FE,Tate LG,Robinsin MJ.Familial fibromuscular dysplasia presenting as sudden death.AM J Cardiovascular Pathology,1988,2(2): 269-271.
23.Genest J.Hypertension's physio-pathology and Treatment: Renovascular hypertension.New York: Mcgraw-Hill Book Company,1977:815.
24.阮英茆,程显声,陈白屏等。肺动脉纤维肌性结构不良引起的肺心病两例。中华病理学杂志,1998,27(5): 396-397.
25.Sen P,Thakur N,Stockton DW,et al.Expanding the phenotype of alveolar capillary dysplasia(ACD).J Pediatr,2004,145(5): 646-651.
26.阮英茆,程显声,司文学,等.心肺血管病并发较大肺动脉血栓阻塞100例尸检的临床病理分析。中华结核和呼吸杂志,1991,14(1):7.
27.阮英茆,吴遐,程显声,等.慢性肺原(源)性心脏病40例尸检临床病理对照分析。心脏血管疾病,1978,6:130-134.
28.Bradley SP,Auger WR,Moser KM,et al.Right ventricular pathology in chronic pulmonary hypertension.AM J Cardiology,1996,78(5): 584-587.
29.Degano B,Sitbon O,Simonneau G.Pulmonary arterial hypertension and HIV infection.Respir Critical Care Med,2009,30(4): 440-447.
第二节 肺动脉栓塞病理学
一、概述
(一)肺动脉栓塞的类型及病理形态
引起肺动脉栓塞主要的原因是下肢深静脉血栓脱落,不同口径的肺动脉栓塞产生的结果也不同。外周肺小动脉栓塞常常没有症状,只在尸检时偶然发现。反复发生的肺小动脉栓塞会引起肺动脉高压。大的肺动脉血栓栓塞会引起右心功能衰竭、低血压和循环衰竭而猝死。病理学上,急性肺动脉血栓栓塞,肉眼及显微镜下可见左、右肺动脉及肺内小动脉内充满暗红色血栓物质(图3-2-1, 图 3-2-2)。

图3-2-1 肺动脉内充满暗红色血栓组织

图3-2-2 较大肺动脉内充满新鲜血栓(主要含纤维素、白细胞)(HE染色,低倍放大)
慢性栓塞时,肺动脉内膜增厚,多为机化血栓(图3-2-3)。血栓可以再通,在原有机化血栓基础上又可见新鲜血栓形成(图3-2-4,图3-1-8)。

图3-2-3 肺动脉血栓机化(HE染色,低倍放大)
除血栓栓塞外,其他物质也可引起肺动脉栓塞,如肿瘤栓子、羊水、脂肪、寄生虫等。在恶性肿瘤患者,肺动脉肿瘤栓塞很常见,但很少引起肺动脉广泛栓塞而导致肺动脉高压。这些患者往往死于恶性肿瘤本身而非肺动脉高压。在个别情况下,广泛的肿瘤栓塞(通常来源于转移性乳腺癌、胃癌和肺癌)可导致亚急性肺动脉高压。病理学上,先是表现肺动脉肿瘤性微栓子和血栓性微血栓混合栓塞,然后是肿瘤性微栓为主,最后,部分病例表现为肿瘤性微栓和巨大的血栓栓塞。位于右心房或右心室的黏液瘤也有可能产生肺动脉栓塞。

图3-2-4 肺动脉内新鲜及机化血栓(HE,低倍放大)
原发肺动脉血栓形成非常罕见,可以发生在肝素引起的血小板减少症,肺动脉高压和肺动脉粥样硬化基础上。
肺动脉血栓形成及/或栓塞病引起肺毛细血管床破坏、肺细小动脉中层肥厚、内膜纤维化狭窄或闭塞。
没有可靠的标准区别是原位血栓形成,还是栓塞,一般认为,大肺动脉的血栓阻塞可能来自栓塞,常为急性;肺动脉末梢分支血栓阻塞可能是原位的血栓形成。肌型肺动脉血栓很可能是原发的,虽然肺小动脉广泛的微栓也可从大块血栓崩解而来。慢性血栓性肺动脉病常常伴发肺动脉高压,血栓的病理变化特征是不规则的、非板层状闭塞性内膜纤维化,有机化再通的血管,有时为血管内纤维性单一分隔或网状分隔。可伴有肺毛细血管芽增生,像丛状。血栓后病变的可逆性是很有限的。有的病人临床有不能解释的肺动脉高压,其肺肌型动脉有多个新旧血栓阻塞;但其体静脉无栓塞病史,此种被称为安静型反复发生的血栓栓塞性肺动脉高压(silent recurrent thromboembolism pulmonary hypertension),又可称为慢性血栓栓塞性肺动脉高压(CTEPH)。此种微栓可能由于原发的血栓形成,而不是栓塞。我们也遇到过此种原因不明的特发性肺动脉高压,临床误诊为先天性心脏病或间质性肺病。在血栓后的肺小动脉纤维斑块内可见含铁血黄素沉着或钙化。在有些血栓阻塞型肺动脉高压病例,肺小动脉中层肥厚不如动脉性肺动脉高压那样的明显,而以内膜纤维化及血栓改变明显。
(二)血栓的病理进展性变化
据国外的有关实验报道,机体对血栓有自溶作用,少量小块血栓栓子2~3周会自溶消失。血栓如不溶解,血管及其滋养血管扩张,约12小时后会有纤维素覆盖表面,约24小时后有内皮细胞开始覆盖,局部动脉中膜水肿,中性粒细胞浸润入血栓附着的内膜面,动脉内弹力板开始被破坏。2~3天血栓与内膜粘连,内皮细胞植入血栓内。一周后血栓明显机化反应,纤维肌母细胞、纤维母细胞、内皮细胞、新生毛细血管增生,中性粒细胞浸润渐减少,淋巴细胞渐增多,有含铁血黄素的吞噬细胞、单核细胞、浆细胞浸润。2~3周后血栓机化反应使其能牢固地与局部动脉壁粘连,血栓有纤维肉芽组织、新生小血管,使血栓机化再通。机化血栓有的呈偏心性纤维化,或完全纤维化闭塞,或管腔内膜纤维化增厚,被一纤维条状分隔成双腔,或筛孔状再通。受累动脉内膜弹力板可崩解、分裂变细、减少。
二、肺栓塞发生率及临床诊断与病理符合率
(一)发生率
肺动脉栓塞及血栓形成可见于各种疾病,文献报道发生率占尸检的1.5%~64%,显微镜检出率为52%~90%,占我院连续尸检的11%。分析阜外医院100例肺栓塞致死尸检资料,其中76%并发肺梗死(pulmonary infarction),以右下肺较多(占42%),35%发生了猝死,生前诊断并发肺栓塞者仅占13%。在本院100例心、肺、血管疾病的尸检中,致死性肺栓塞的发生率占慢性风湿性心脏病尸检的29%,扩张型心肌病的26%及COPD肺原心脏病的19%。高血压性心脏病、冠状动脉粥样硬化性心脏病并发致死性肺栓塞的发生率分别为2%、4%。
(二)生前临床诊断致死性肺栓塞与病理诊断符合率
作者在阜外医院1991年报道的100例尸检中,临床生前诊断与尸检符合率为13%。在近10年病理收集到的10例较大肺动脉血栓阻塞中,仅2例(1/5)临床肺栓塞诊断与病理符合。国外1999年有报道,病理解剖证实为肺栓塞中的11%~25%生前被临床确诊,致死性肺栓塞临床诊断正确率仅1/3。从阜外医院近些年的尸检和外科切除的慢性肺动脉血栓阻塞性肺动脉高压(CTEPH)的标本分析,较大肺动脉的致死性血栓阻塞,临床诊断与病理诊断符合率为45%。有报道,在外科切除的肺栓塞病例约有10% ~20%患者遗留持久性PH(即CTEPH),这些病例的肺活检证明存在肺微小动脉血栓阻塞,而临床现有医技手段未能发现。总之,尽管临床诊断器械检查技术有了很大的发展,但肺栓塞的生前确诊率仍很低。在原有心肺血管病或心肺肿瘤、肺炎者,如发现用原发病不好解释的诊疗困难时,应想到肺栓塞并发症,进一步通过现代先进技术手段检查,及时进行正确的诊断和治疗。据发达国家报道认为,尸检或肺活检是诊断肺栓塞的金标准。我们体会,肺栓塞病人血液脱落内皮细胞(图3-2-5)数目的检查可能对发现肺栓塞及血管炎有帮助、而且容易执行。对病情复杂难以确诊的慢性肺动脉高压病例,可争取开胸取肺活检组织行病理检查。总之,多争取尸检或肺活体组织检查,对临床提高肺栓塞和CTEPH诊疗水平肯定会有其他方法不可取代的帮助。

图3-2-5 肺静脉栓塞患者死前静脉血内皮细胞增多(中倍放大)
(李莉 阮英茆)
参考文献
1.王辰。肺栓塞。北京:人民卫生出版社,2003:125-129.
2.阮英茆,司文学,张连庄。肺血栓栓塞症10例临床病理分析。中华结核和呼吸杂志,2003,26(2):81-83.
3.Wagenvoort CA.Pathology of pulmonary thromboembolism.Chest,1995: 107(1): 10s-17s.
第三节 肺动脉肿瘤病理学
肺动脉肿瘤根据其位置可分为腔内肿瘤和附壁肿瘤,文献报道的原发性肺动脉肿瘤较为罕见且均为肉瘤,目前的研究多为个案报道。一些作者认为其真实的发生率尚不清楚,但是有可能被低估,因为许多病例被误诊,而正确的诊断则必须依靠病理学观察。病人的症状多为咳嗽、气短、胸痛,因症状缺乏特征性,往往误诊为肺动脉栓塞并实施血栓剥离术。
肺动脉肿瘤大体形状为柔软分叶状(图3-3-1),或呈坚实骨性,多数文献报道为黏液样,其病理类型多样,内膜肉瘤最多(34%),其次为纤维肉瘤或纤维黏液肉瘤(21%)、平滑肌肉瘤(20%)、横纹肌肉瘤(6%)、间叶瘤(6%)、软骨肉瘤(4%)、血管肉瘤(4%)、骨肉瘤(3%)及恶性纤维组织细胞瘤(2%)。也有报道平滑肌肉瘤最多。作者总结阜外医院自1956年至今6例肺动脉肉瘤病例发现内膜肉瘤最为多见(4/6,67%),恶性纤维组织细胞瘤1例(图3-3-2),骨肉瘤1例(图3-3-3)。肺动脉肉瘤一般多在腔内沿肺动脉向远端生长而不侵犯外膜,有时甚至延伸至右心室流出道。另有报道,近50%的病例肿瘤外向透壁生长侵犯毗邻肺组织、支气管壁、淋巴结,甚至心肌、纵隔。

图3-3-1 肺动脉肉瘤呈分叶状,突向管腔,局部为黏液样
图3-3-2 肺动脉内恶性纤维组织细胞(HE染色×高倍放大)

图3-3-3 肺动脉内骨肉瘤(HE染色×高倍放大)
一、内膜肉瘤
(一)定义
世界卫生组织(WHO)对内膜肉瘤的定义为发生在体循环和肺循环大动脉壁的恶性间叶肿瘤。主要在血管腔内生长并阻塞血管腔,并可产生肿瘤性栓子,发生外周器官栓塞或种植是其特征性表现。内膜肉瘤主要发生在成年人,发病年龄广。肺动脉内膜肉瘤诊断时的平均年龄为48岁。
(二)发病部位
发生在肺动脉内膜肉瘤常位于肺动脉主干(80%),右或左肺动脉(50% ~70%)或两者同时受累(40%)。有些肿瘤同时累及肺动脉瓣或蔓延至右心室流出道。40%患者直接浸润或转移至肺,约20%病例由胸腔外扩散,累及肺、肾、淋巴结、大脑和皮肤。
(三)临床特征
内膜肉瘤的临床表现常无特异性,症状与肿瘤栓子形成有关,因本瘤罕见,故常常被诊断为复发性肺动脉栓塞性疾病。常规影像学检查经常无特异性发现,对于那些表现为单侧肺动脉阻塞,缺乏血液高凝状态或血栓栓塞病史的患者,应高度怀疑肿瘤(图3-3-4)。CT可以帮助鉴别肺动脉肉瘤与肺动脉栓塞,肺动脉肉瘤通常表现为主肺动脉或远端腔内完全性阻塞性充盈缺损,可向远端蔓延或腔外膨胀。有报道 MRI或 18 氟-2-脱氧-D-葡萄糖PET(PDG-PET)对诊断有帮助。

图3-3-4 肺动脉内膜肉瘤
CT示左、右肺动脉充盈缺损,临床误诊为肺动脉血栓栓塞(LPA:左肺动脉;RPA:右肺动脉)
(四)大体检查
内膜肉瘤大部分是与血管壁相连的管腔内息肉样肿物,和血栓非常相似,因肿瘤常常沿受累血管分支向远端蔓延,故而手术时发现肿瘤呈血管腔铸型(图3-3-5,图3-3-6)

图3-3-5 肺动脉肉瘤,肿瘤沿血管分支生长,呈血管腔铸型
(五)组织病理学
内膜肉瘤一般是成纤维细胞或肌纤维母细胞分化的低分化恶性间叶组织细胞肿瘤,由异形性、分裂活性、坏死和核多形性程度不等的非典型性梭形细胞构成。有些肿瘤含有由上皮样细胞构成的大片黏液样区域。梭形或束状肿瘤细胞明显时可类似平滑肌肉瘤。少数病例可含有横纹肌肉瘤、血管肉瘤或骨肉瘤分化区(图3-3-7,图3-3-8)。

图3-3-6 肺动脉内膜肉瘤,肿瘤组织呈细乳头状,半透明胶冻样

图3-3-7 内膜肉瘤,肿瘤细胞呈短梭形,有些区域细胞呈上皮样,细胞异形性明显,可见瘤巨细胞(HE染色×高倍放大)

图3-3-8 内膜肉瘤,肿瘤含有较多黏液样基质,瘤细胞呈梭形,异形性明显,可见核分裂像(HE染色×中倍放大)
(六)免疫表型
内膜肉瘤未分化的肿瘤细胞一般波形蛋白和osteopontin免疫反应阳性。也曾观察到SMA不同程度阳性,某型肿瘤结蛋白一定程度阳性。血管标记物CD31、CD34和Ⅷ因子在典型的内膜肉瘤中阴性,但在血管肉瘤分化区可阳性(图3-3-9,图3-3-10)。

图3-3-9 内膜肉瘤肿瘤细胞vimentin阳性(免疫组织化学SP染色,中倍放大)

图3-3-10 内膜肉瘤肿瘤细胞SMA阳性(免疫组织化学SP染色,中倍放大)
(七)超微结构
内膜肉瘤的超微结构特点符合肌纤维母细胞性分化,可见微丝、密体和不连续的外板(图3-3-11)。
(八)预后
内膜肉瘤患者平均生存期为13~18个月,手术和辅助治疗可延长生存期,但一般仍预后差。
二、其他肺动脉肉瘤
发生于肺动脉其他类型的肉瘤如恶性纤维组织细胞瘤、平滑肌肉瘤、骨肉瘤、纤维肉瘤、横纹肌肉瘤等都具有与发生于身体其他部位的肿瘤相似的组织病理学表现,但因发生部位罕见,病理诊断时容易误诊。

图3-3-11 透射电镜示内膜肉瘤肿瘤细胞内含有大量微丝,符合肌纤维母细胞分化(TEM)
三、个案分析
患者,男,45岁,胸闷、气急2年,晕厥1次。因行心肺胸片X线照相、右心导管、超声心动图、放射性核素肺灌注显像、超高速CT检查,均诊断为慢性肺栓塞,重度肺动脉高压,肺源性心脏病。一直在内科按慢性肺栓塞诊治,2年间住院2次,第一次住院时被放置了下腔静脉滤器。因内科治疗未能阻抑病情发展,第2次住院由内科转外科行肺栓塞手术治疗。心外科手术发现肺动脉及分支为肿瘤样组织占据,手术摘除肺动脉树枝状肿物,行肺动脉瓣置换。术后病情改善出院。
病理检查:标本为灰白色、质韧的分支状肿物2个,共重70g(图3-3-5),镜下有增生的黏液样纤维、平滑肌样纤维及致密的胶原纤维束,瘤细胞核大,深染,大小不一,多见核分裂象;瘤细胞多为长梭形、短梭形或不规则形,胞质丰富。瘤内含较多的新生小血管(图3-3-2)。瘤组织侵入肺动脉内膜、中膜,与肺动脉壁无分界。未见血栓成分。免疫组织化学染色:Vimentin(+),SM-actin(+),F-Ⅷ(+),EMA(-),CK(-),Sarcomeric actin(-)(图3-3-9, 图3-3-10)。
病理诊断:主肺动脉及其左、右分支内膜肉瘤,侵入肺动脉内膜、中膜层。
讨论:关于肺血管肿瘤、肺栓塞的临床表现及影像检查特异性不强,临床医师常忽视(或未想到):有的肺血管肿瘤被误为肺栓塞或先天性心脏病(肺动脉瓣狭窄),甚至置放了下腔静脉滤器。应吸取的教训是:①对于肺血管阻塞性病变,如诊断肺栓塞依据不足,不要置放静脉滤器;②外科在行此类肺动脉(瓣)手术前如不能明确诊断,要做好相关复杂手术准备,术前行冷冻切片病理检查确诊。
(李莉)
参考文献
1.Bleish VR,Kraus FT.Polypoid pulmonary artery sarcoma of the pulmonary trunk:analysis of the literature and report of a case with leptometric organells and ultrastructural features of rhabdomyosarcoma.Cancer,1980,46(2): 314-324.
2.Cox JE,Chiles C,Aquino SL,et al.Pulmonary artery sarcomas:A review of clinical and radiologic features.J Comput Assist Tomogr,1997,21(5): 750-755.
3.Yi ES.Textbook of Pulmonary Vascular Disease:Tumors of the pulmonary vascular bed.Boston: Springer,2011:1343-1353.
4.弗莱彻.软组织与骨肿瘤病理学和遗传学.程红,金木兰,李增山,等译.北京:人民卫生出版社,2006:260-262.
5.Choi EY,Yoon YW,Kwon HM,et al.A case of pulmonary artery intimal sarcoma diagnosed with multislice CT scan with 3D reconstruction.Yonsei Med J,2004,45(3): 547-551.
6.Kim JH,Gutierrez FR,Lee EY,et al.Primary leiomyosarcoma of the pulmonary artery:a diagnostic dilemma.Clin Imaging,2003,27(3): 206-211.
7.Anderson MB,Kriett JM,Kapelanski DP,et al.Primary pulmonary artery sarcoma:a report of six cases.Ann Thorac Surg,1995,59(6): 1487-1490.
8.Huo L,Moran CA,Fuller GN,et al.Pulmonary artery sarcoma:a clinicopathologic and immunohistochemical study of 12cases.Am J Clin Pathol,2006,125(3):419-424.


